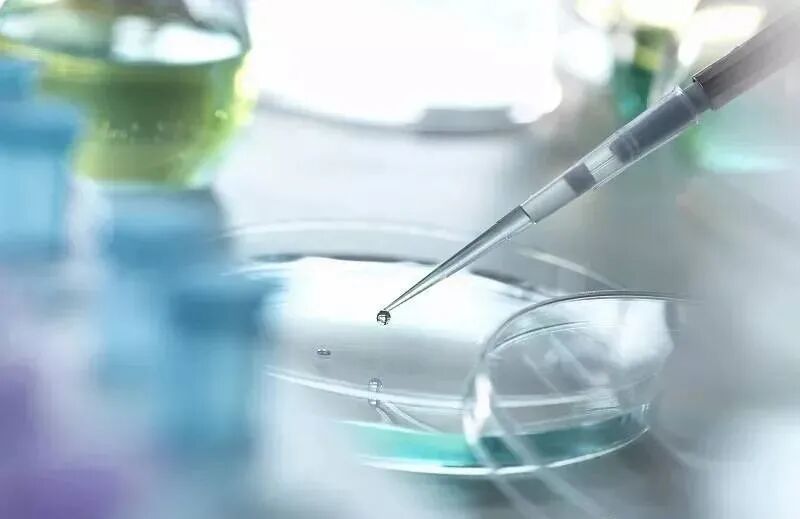
ͼƬ

国际权威医学期刊《美国骨科与运动物理治疗杂志》研究发现;





近年来,干细胞治疗骨关节炎(OA)已成为研究的热点。基于组织修复、免疫调节和抗氧化等作用,干细胞疗法在骨关节炎疾病领域取得了重要进展。①干细胞具有高度自我增殖和多向分化潜能,低免疫原性无MHC限制性,来源丰富可取脐带组织,损伤趋向化作用及“归巢”功能;②加上免疫调节和损伤修复特性,在机体内可分泌大量生长因子和免疫调节因子促进修复组织损伤,抑制炎症和自身免疫反应,因此干细胞成为治疗关节炎的另一种选择。③干细胞拥有强大的自我更新增殖能力及分化潜能,能在体内微环境作用下主动迁移至受损部位进行修复重建,并且可分泌多种生物活性分子,刺激软骨细胞的增殖。
案例一:王等将30例0A患者通过关节镜行关节腔清理后在关节腔内注射干细胞,经过2年随访,疗效显著,不但疼痛缓解,而且功能也明显改善,最后通过关节镜检查证实其可有效促进软骨再生。案例二:黄等报道18例0A患者,在膝关节腔内注射干细胞,经过6个月治疗后,膝关节疼痛明显减轻,而活动度也增加,通过磁共振成像显示原膝关节软骨缺损处软骨厚度增加;通过关节镜检查确认原软骨缺损区域有了光滑的新生软骨,没有发现与实验相关的不良反应,证明了干细胞治疗0A的安全性。案例三:Zhao等研究显示从脐带中提取干细胞注入膝关节腔后,3个月时疼痛明显改善,6个月时达到最好的临床结果。案例四:Ling等使用干细胞多次膝关节腔内注射治疗膝0A,经过平均96周的随访发现疼痛症状、膝关节功能及软骨面积方面都取得了明显改善。

国内干细胞疗法对膝骨关节炎的临床研究备案进展:截至2021年11月底,国内干细胞临床研究项目已达111个!其中干细胞疗法在关节炎的临床研究项目多达7项!此再次展示了干细胞在骨关节炎领域的临床应用前景。目前干细胞治疗骨关节炎已成为当前的研究热点,而且取得了不错的效果,随着干细胞技术的发展,干细胞治疗骨关节炎越来越被认为是一种极具前景的治疗方式。相信不久的将来,全球更多的骨关节炎患者将能够受益于干细胞技术。
上海本正生物工程有限公司提供的干细胞是从脐带、胎盘中提取的一种修复器官机理的未完全分化的原始细胞,具有自我更新、多项分化和高度繁殖的能力,医学上称为“万能细胞”,它是形成人体各种组织器官的起源细胞。干细胞对临床上一些疑难疾病的治疗如:脑瘫、老年痴呆、脑萎缩、帕金森病、中风、肝硬化、糖尿病、红斑狼疮、股骨头坏死、软骨和关节损伤、心脏和脊髓损伤等,取得显著效果,它拥有更加鲜活细胞能量,可以快速、有效进入体内,分泌多种有益细胞因子,调节体内微环境,激活干细胞再生能力,重启时光之门,追溯青春绽放源头,实现对人体衰老状态减缓,同时有效改善身体亚健康以及预防肿瘤发生。

|
